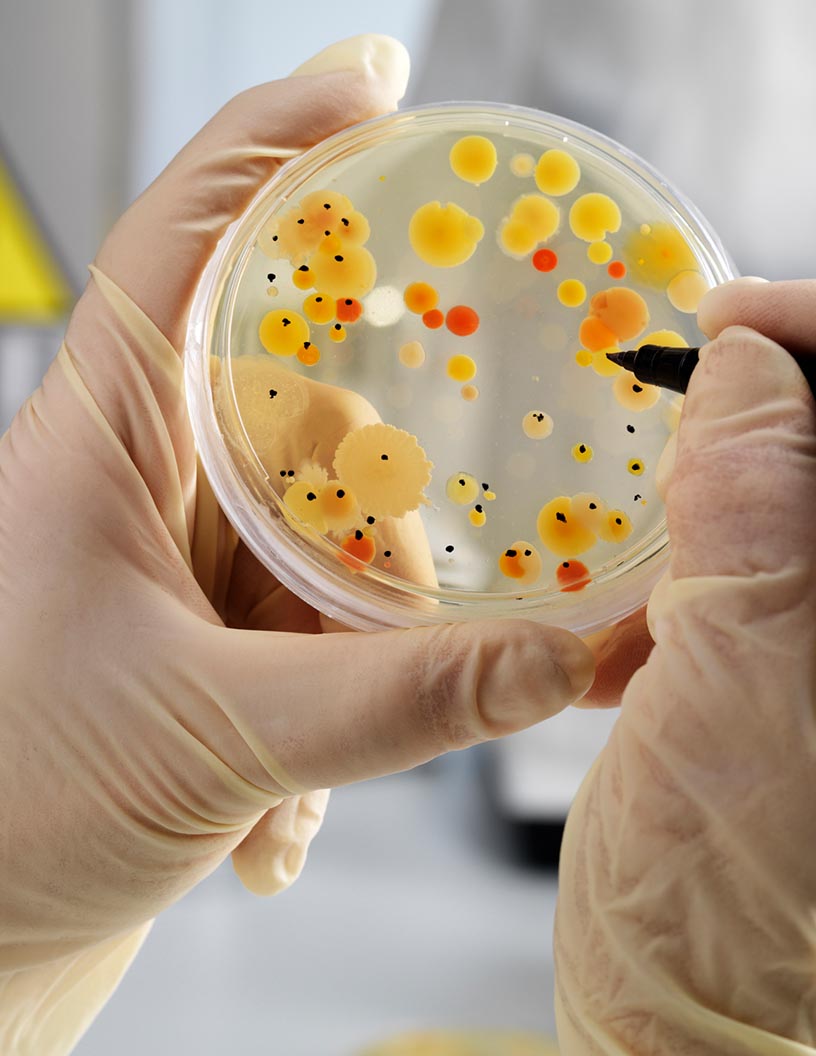
Agar Market Analysis Europe, North America, APAC, Middle East and Africa, South America - US, China, Germany, UK, France - Size and Forecast 2024-2028

Agar Market Size 2024-2028
The Agar market size is forecast to increase by USD 38 million at a CAGR of 3.2% between 2023 and 2028. The market is witnessing significant growth due to the rising demand for dairy goods and the increasing popularity of plant-based gelatin substitutes in sauces and food formulations. Agar, a gelling ingredient derived from red algae, is gaining traction as a sustainable alternative to man-made gelling agents like carrageenan and pectin. Seaweed supplies and Agar processing facilities are expanding to meet the increasing demand. The market trends include the form of Agar, with strips and powders being commonly used in various food and beverage applications. Climate change and seaweed species selection are crucial factors affecting the market. Agar's versatility in creating gel strength and its use in bacteriological applications further broaden its market reach.
Furthermore, liquid Agar is increasingly being used in research and diagnostic laboratories for microbiological culture media. The price fluctuations of Agar and its derivatives are a challenge for market growth, but the potential health benefits and sustainability of Agar are driving its adoption in various industries.
Agar, derived from red algae seaweeds such as Gracilaria and Gelidium, is a popular vegan alternative to gelatin. This gelatin-like substance, extracted from the seaweeds, possesses excellent gelling properties, making it an ideal choice for various industries. Agar has a long shelf life and is widely used in bacteriological culture media due to its ability to solidify and provide a stable environment for bacterial growth. In the food industry, Agar is utilized as a thickening agent, clarifying agent, stabilizer, and wrapping material in various applications. It is commonly used in confectionery to make meringues, cakes, buns, and pastries. Agar is also used in the production of non-stick icing and wine, where it acts as a stabilizer. In the cosmetics industry, Agar is used as a gelling agent and is beneficial for those following a vegan lifestyle. In medicine and dentistry, it is used as a gelling agent and a substitute for gelatin in various applications.
Market Segmentation
The market research report provides comprehensive data (region-wise segment analysis), with forecasts and estimates in "USD million" for the period 2024-2028, as well as historical data from 2017-2022 for the following segments.
- Product Type
- Powders
- Flakes
- Sheets
- Application
- Food and beverages
- Pharmaceuticals
- Others
- Geography
- Europe
- Germany
- UK
- France
- North America
- US
- APAC
- China
- Middle East and Africa
- South America
- Europe
By Product Type Insights
The powders segment is estimated to witness significant growth during the forecast period. Agar powder, derived from 100% natural Red Seaweed, serves multiple functions as a gelling, thickening, stabilizing, and emulsifying agent in various industries. In the realm of Bacteriological culture media, it is utilized as a clarifying agent due to its diffusion property. In the cosmetics, medicine, and dentistry sectors, Agar is employed as a stabilizing agent for pharmaceuticals and cosmetic formulations, providing essential minerals, vitamins, iron, iodine, calcium, and phosphorous. In the food industry, Agar is used as a substitute for gelatin in wine production as a thickening agent, and in pastries, ice-creams, salad dressings, desserts, and other food items for its stabilizing properties. TIC Gums (Ingredredion Inc.), a US-based manufacturer, is a significant player in the market, supplying this versatile ingredient to various industries.
Get a glance at the market share of various segments Request Free Sample
The powders segment was valued at USD 114.60 million in 2018 and showed a gradual increase during the forecast period.
Regional Insights
Europe is estimated to contribute 42% to the growth of the global market during the forecast period. Technavio's analysts have elaborately explained the regional trends and drivers that shape the market during the forecast period.
For more insights on the market share of various regions Request Free Sample
Agar, a bacteriological culture media derived from red algae, holds significant importance in various industries, including cosmetics, medicine, dentistry, and food and beverages. In the food sector, Agar functions as a clarifying agent, thickening agent, stabilizing agent, and even a substitute for gelatin in numerous applications. Its usage extends to diverse food categories, such as pastries, ice-creams, salad dressings, desserts, and wines. Moreover, Agar's minerals, vitamins, iron, iodine, calcium, and phosphorous content contribute to its nutritional value. In Europe, the food and beverage industry's major contributors are Russia, Germany, and the UK. The UK market is particularly driven by the increasing trend towards veganism and vegetarian ingredients, consumer preference for natural and functional foods, and convenience.
Furthermore, Agar's versatility and wide application in various food and beverage categories make it a valuable ingredient. Additionally, its kosher certification makes it suitable for a significant portion of packaged food items in the region. Thus, the market in Europe is poised for strong growth during the forecast period.
Our researchers analyzed the data with 2023 as the base year, along with the key drivers, trends, and challenges. A holistic analysis of drivers will help companies refine their marketing strategies to gain a competitive advantage.
Market Driver
Rising demand for dairy products is the key driver of the market. Agar, derived from red algae seaweeds such as Gracilaria and Gelidium, is a popular vegan alternative to gelatin in various industries. Agar is a natural, gelatin-like substance that offers similar gelling properties without the ethical concerns associated with animal derivatives. This versatile ingredient is widely used in the food industry, particularly in dairy products like yogurt, cheese, creams, custard, spreads, curd, mousses, puddings, infant formula, and smoothies. Agar's ability to jellify, thicken, and stabilize food items at low concentrations (as low as 0.04%) without technical support makes it an essential ingredient in the dairy industry. Its non-nutritive characteristics cater to the growing demand for sugar-free, fat-free, and carbohydrate-free products.
Furthermore, Agar 's applications extend beyond the food industry, with uses in pharmaceuticals and nutraceuticals for appetite suppressants, weight loss, digestive health, and bone health. Its long shelf life and thermal stability make it a preferred choice for manufacturers.
Market Trends
The increasing prominence of private-label brands is the upcoming trend in the market. Agar, a gelatin-like substance derived from red-algae seaweeds such as Gracilaria and Gelidium, is gaining popularity in various industries due to its unique gelling properties. This vegan alternative to gelatin is widely used in food and beverage applications, including confectionery, baked goods, and pharmaceuticals & nutraceuticals. Agar is available in different forms, including powder and flakes, and is used in formulations and dry blends for various applications. The growing trend towards veganism and health-conscious eating has fueled the demand for Agar as an appetite suppressant and for weight loss and digestive health. Agar is also known to support bone health.
Furthermore, major retailers, recognizing this trend, are introducing their own private-label brands of Agar to cater to the increasing demand. These retailers are selling Agar in various forms, contributing to the growth of The market. The private-label product segment has seen significant growth in the last decade, with retailers capitalizing on the demand for gluten-free confectioneries and individual consumers seeking healthier alternatives.
Market Challenge
Price fluctuations are a key challenge affecting market growth. Agar, a gelatin-like substance derived from red algae seaweeds, including species such as Gracilaria, Gelidium, and others, exhibits excellent gelling properties and is widely used in various industries. However, the production and supply of Agar are subject to several challenges. The primary constraint is the scarcity and limited yield of red algae, which are the base raw materials. High price fluctuations in the market are a result of this scarcity and the complex process of extracting from the seaweed. Furthermore, regulatory restrictions imposed by governments on the supply of certain Agar varieties, such as technical LP0013 and bacteriological LP0011, impact the market.
Furthermore, these factors contribute to the high price point of Agar and its derivatives, including powders, flakes, formulations, dry blends, and pharmaceuticals & nutraceuticals. Agar is valued for its applications in weight loss, appetite suppressants, digestive health, bone health, and other areas. Despite these challenges, the market for Agar and its derivatives is expected to grow due to increasing demand from various industries and the expanding vegan and vegetarian population.
Exclusive Customer Landscape
The market forecasting report includes the adoption lifecycle of the market, covering from the innovator's stage to the laggard's stage. It focuses on adoption rates in different regions based on penetration. Furthermore, the report also includes key purchase criteria and drivers of price sensitivity to help companies evaluate and develop their market growth analysis strategies.
Customer Landscape
Key Companies & Market Insights
Companies are implementing various strategies, such as strategic alliances, partnerships, mergers and acquisitions, geographical expansion, and product/service launches, to enhance their presence in the market.
Titan Biotech Ltd.- The company offers Agar in the form of powder named Chromogenic Coliform Agar and in the form of liquid named Sabouraud dextrose Agar.
The market research and growth report includes detailed analyses of the competitive landscape of the market and information about key companies, including:
- Agar Gel
- Agramex SA de CV
- Ases Chemical Works
- B and V srl
- Central Drug House Pvt. Ltd.
- HispanAgar S A
- INDUSTRIAS ROKO SA
- Ingredion Inc.
- Merck KGaA
- Meron Group
- MSC Co. Ltd.
- Myeong Shin Agar Agar Co. Ltd.
- Neogen Corp.
- New Zealand Manuka Group
- Orient Resources Co.
- PT. Agar Swallow
- PT. Agar indo Bogatama
- PT Surya Indoalgas
- SETEXAM SA
- Titan Biotech Ltd.
Qualitative and quantitative analysis of companies has been conducted to help clients understand the wider business environment as well as the strengths and weaknesses of key market players. Data is qualitatively analyzed to categorize companies as pure play, category-focused, industry-focused, and diversified; it is quantitatively analyzed to categorize companies as dominant, leading, strong, tentative, and weak.
Research Analyst Overview
Agar, a gelatin-like substance derived from red-algae seaweeds such as Gracilaria and Gelidium, is a versatile gelling agent used in various industries. Its gelling properties make it an ideal substitute for gelatin in numerous applications. Agar is known for its high-temperature resistance capacity and stability, making it suitable for use in food, cosmetics, pharmaceuticals & nutraceuticals, and bakery industries. In food applications, Agar is used as a thickening agent in dairy products, sweets, candies, sauces, and gelatin substitute in dietetic products. It is also used as a clarifying agent in wine and a stabilizer in non-stick icing. In the bakery industry, Agar is used in pie fillings, icings, meringues, cakes, buns, and wrapping materials.
Furthermore, Agars is rich in minerals, vitamins, iron, iodine, calcium, and phosphorous, making them a popular choice for foodstuffs. Agar's diffusion property provides clarity and adhesiveness, making it a preferred choice in the confectionery industry for fruit candies and tasteless food formulations. Agar is also used as a substitute for man-made gelling agents like carrageenan and pectin. In cosmetics and medicine, Agar is used as a bacteriological culture media and in dentistry as a tissue engineering substance. It is also used as a stabilizing agent in liquids and a substitute for gelatin in pharmaceuticals and nutraceuticals. Agars are sourced from various seaweed species, including Gracilaria chilensis, Gelidium, and Rhodophyta. The climate and Agar processing facilities play a crucial role in the quality of Agar. Agar is available in various forms, including strips, powders, and flakes, making it a versatile ingredient for food, cosmetics, and technical applications.
|
Market Scope |
|
|
Report Coverage |
Details |
|
Page number |
157 |
|
Base year |
2023 |
|
Historic period |
2017-2022 |
|
Forecast period |
2024-2028 |
|
Growth momentum & CAGR |
Accelerate at a CAGR of 3.2% |
|
Market growth 2024-2028 |
USD 38 million |
|
Market structure |
Fragmented |
|
YoY growth 2023-2024(%) |
3.06 |
|
Regional analysis |
Europe, North America, APAC, Middle East and Africa, and South America |
|
Performing market contribution |
Europe at 42% |
|
Key countries |
US, China, Germany, UK, and France |
|
Competitive landscape |
Leading Companies, Market Positioning of Companies, Competitive Strategies, and Industry Risks |
|
Key companies profiled |
Agar Gel, Agramex SA de CV, Ases Chemical Works, B and V srl, Central Drug House Pvt. Ltd., HispanAgar S A, INDUSTRIAS ROKO SA, Ingredion Inc., Merck KGaA, Meron Group, MSC Co. Ltd., Myeong Shin Agar Agar Co. Ltd., Neogen Corp., New Zealand Manuka Group, Orient Resources Co., PT. Agar Swallow, PT. Agar indo Bogatama, PT Surya Indoalgas, SETEXAM SA, and Titan Biotech Ltd. |
|
Market dynamics |
Parent market analysis, market growth inducers and obstacles, market forecast, fast-growing and slow-growing segment analysis, COVID-19 impact and recovery analysis and future consumer dynamics, market condition analysis for the forecast period |
|
Customization purview |
If our market report has not included the data that you are looking for, you can reach out to our analysts and get segments customized. |
What are the Key Data Covered in this Market Research and Growth Report?
- CAGR of the market during the forecast period
- Detailed information on factors that will drive the market growth and forecasting between 2024 and 2028
- Precise estimation of the size of the market and its contribution of the market in focus to the parent market
- Accurate predictions about upcoming market growth and trends and changes in consumer behaviour
- Growth of the market across Europe, North America, APAC, Middle East and Africa, and South America
- Thorough analysis of the market's competitive landscape and detailed information about companies
- Comprehensive analysis of factors that will challenge the growth of market companies
We can help! Our analysts can customize this market research report to meet your requirements. Get in touch

RIA -
RIA - 
